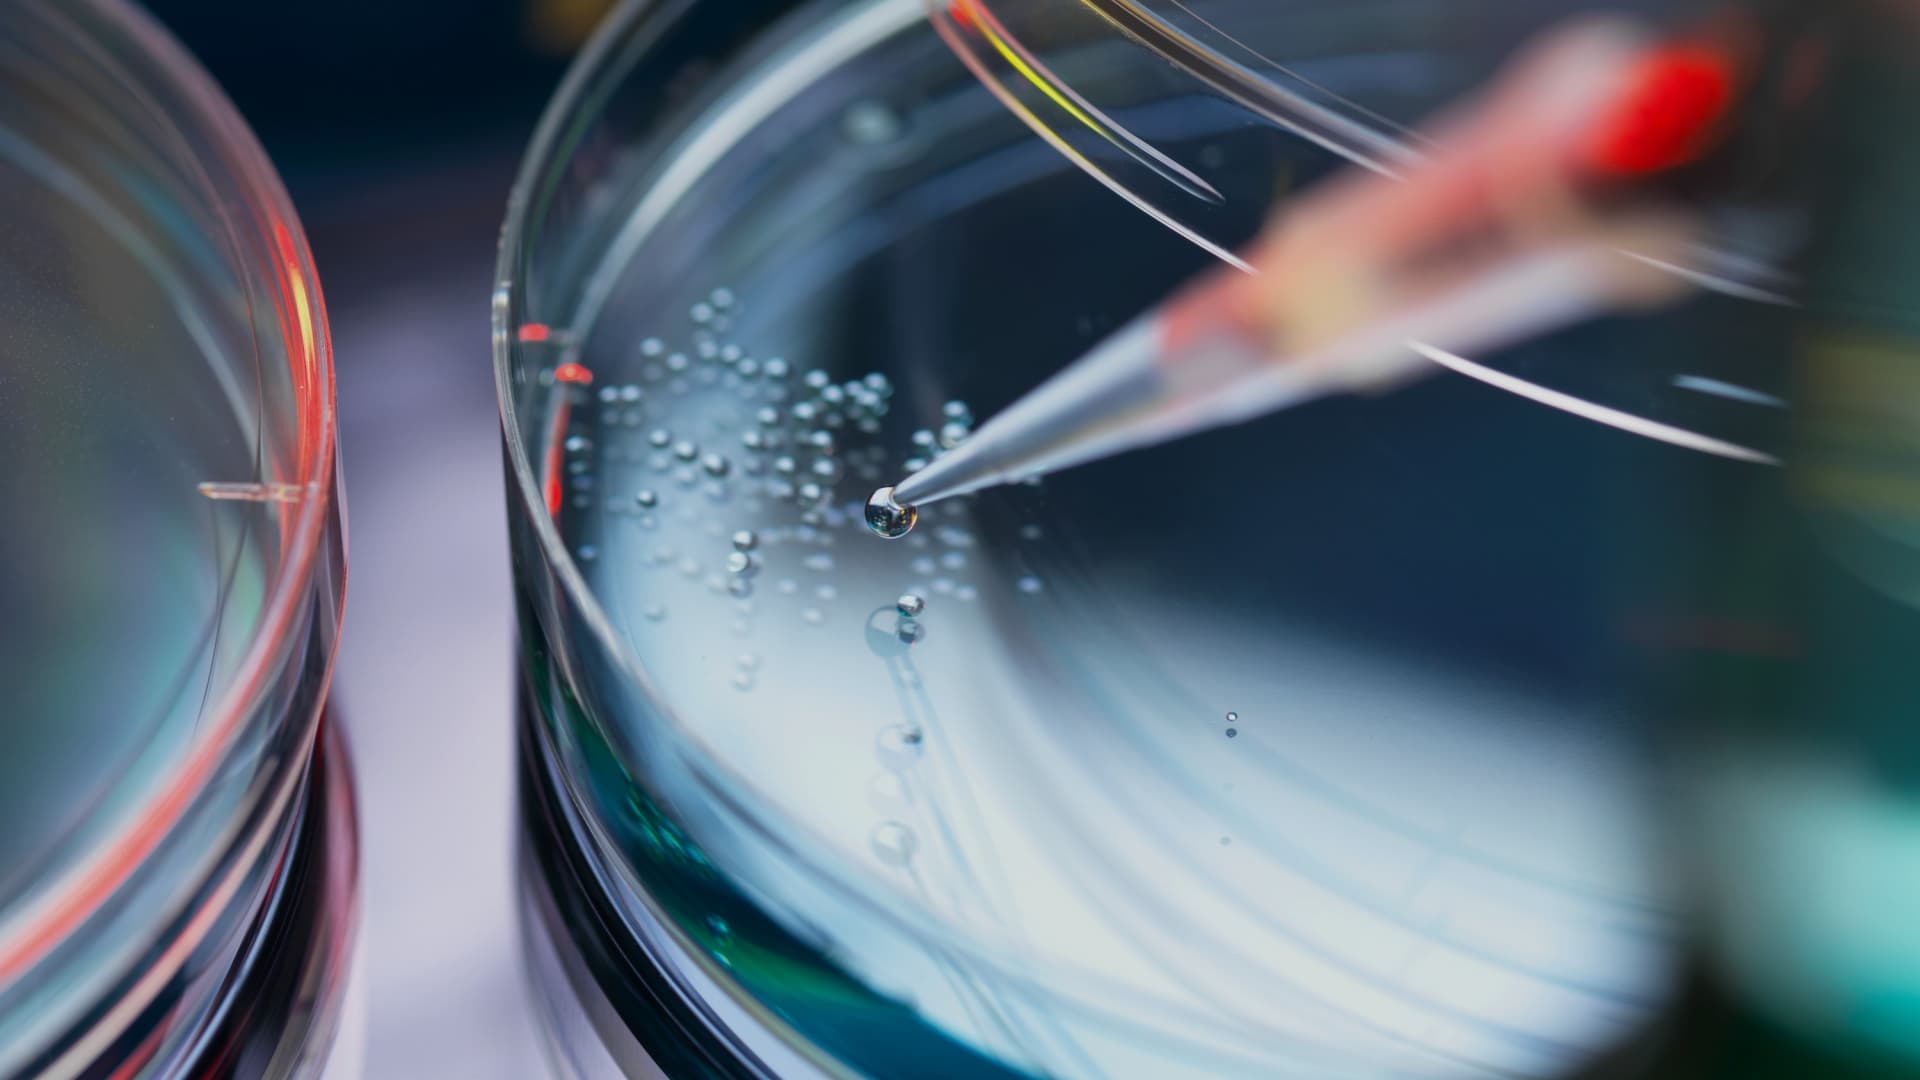

原料へのこだわり
世界から厳選した成分で、内側からすこやかな美しさを
純粋原料
Quality Ingredients
-

UNOMIは、身体が持つ本来のリズムを大切にし、
地球の恵みに感謝しながら、本質的なサポートを大切にしています。
過度な添加物を避け、必要なものだけを厳選。
世界3大陸・30カ国以上から選び抜いた天然素材をもとに、
高濃度かつピュアな成分を配合した製品づくりを行っています。

品質へのこだわり
Quality Control
UNOMIは、科学的な視点と確かな管理体制のもとで、一人ひとりのすこやかな毎日に寄り添う製品をお届けします。
原料の調達から製造・出荷に至るまで、厳格な基準を設け、素材の信頼性と安全性を丁寧に確認しています。

世界から届く、こだわりの原料
Top Supplier
〇日本産ナイアシンアミド原液
〇北大西洋深海産カツオ由来エラスチンコラーゲン
〇インド・カルナータカ州原生林産ギムネマ
〇フランス中部カヴィヨン地方産メロン
〇英国製ビタミンC(シチリア産ブラッドオレンジ由来)
〇その他、世界各国から厳選した植物成分を随時導入中

